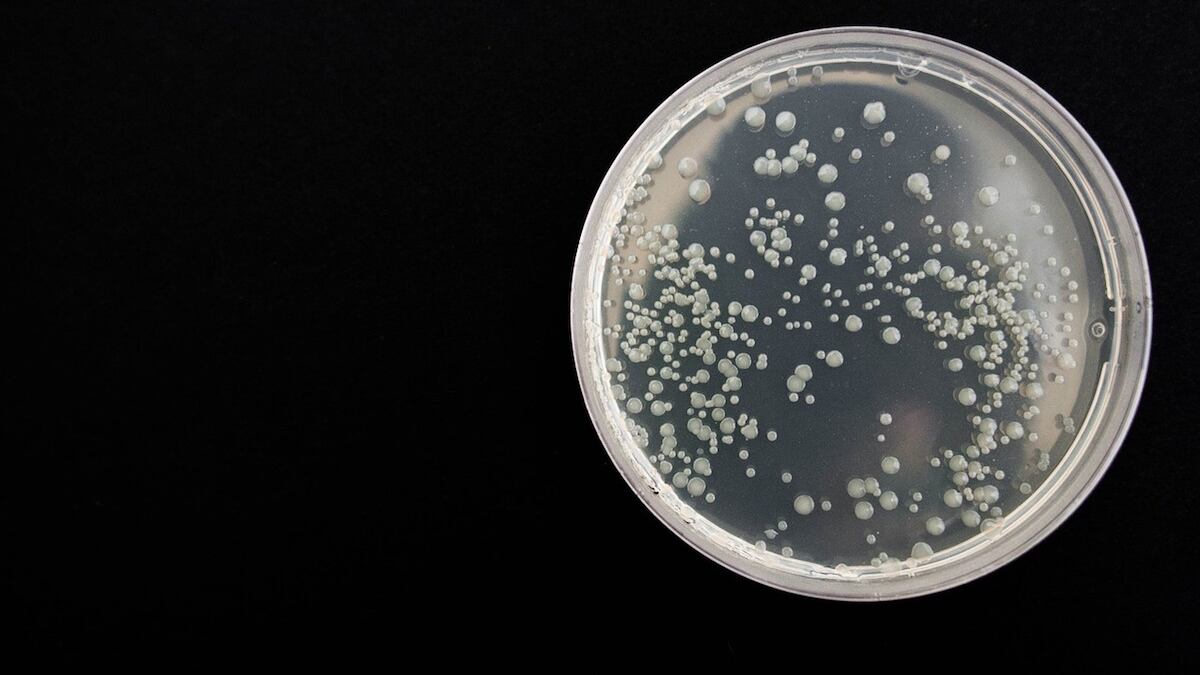
Si no es atendida puede generar diferentes daños. (Pixabay)

Una bacteria mortal con una tasa de mortalidad de aproximadamente el 50% a nivel mundial fue detectada en la costa estadounidense del Golfo de México, donde los Centros para el Control y la Prevención de Enfermedades (CDC) la declararon endémica.
Te puede interesar: Así puedes prevenir las infecciones de vías urinarias tomando jugo de arándano
Los CDC han confirmado tres casos de infección por la bacteria Burkholderia pseudomallei, que puede causar melioidosis potencialmente letal si no se trata.
“Se trata de un organismo ambiental que vive de forma natural en el suelo y, por lo general, en el agua dulce en determinadas zonas de todo el mundo. Sobre todo en climas subtropicales y tropicales”, explicó a HealthDay News Julia Petras, funcionaria del servicio de inteligencia epidémica del Centro Nacional de Enfermedades Infecciosas Emergentes y Zoonóticas de los CDC.
El caso más reciente se registró en Mississippi en enero pasado. Otros dos fueron confirmados en el mismo condado de Mississippi en julio de 2020 y mayo 2022.
Sin embargo, la mayoría de las personas infectadas con la bacteria no muestran síntomas y desarrollan anticuerpos contra ella, lo que significa que es probable que muchas más personas estén infectadas, dijo Petras. En los tres casos de Mississippi, el paciente se recuperó.
“Se trata de una de esas enfermedades que también se conoce como la gran imitadora, porque puede parecerse a muchas cosas diferentes”, declaró Petras al citado medio. “Está muy infradenunciada, infradiagnosticada e infravalorada; a menudo nos gusta decir que ha sido la enfermedad tropical olvidada y desatendida”.
Las personas suelen infectarse con la bacteria a través de heridas abiertas o inhalando los gérmenes durante una fuerte tormenta con vientos fuertes, por lo que se recomienda a la gente en la zona cubrirse sus heridas al salir. Las personas con diabetes o problemas renales o hepáticos son las más expuestas.
“El consumo excesivo de alcohol también es un factor de riesgo conocido, y las borracheras también se han asociado a casos en zonas endémicas”, afirmó Petras.
En el mundo, sólo se han registrado dos casos de propagación de la bacteria de persona a persona.
Una vez en el cuerpo, la bacteria ataca órganos como los pulmones y el cerebro y cualquier órgano con un absceso, explicó Petras.
“Muchos pacientes tendrán neumonía con sepsis, y/o sepsis, que se asocia con una mayor mortalidad y peores resultados”, dijo.
Al año se registran en promedio unos 160 mil casos, con 80 mil decesos. Entre más pronto se diagnostica la enfermedad, es más fácil que el paciente sea atendido adecuadamente y sobreviva.
Se trata de una bacteria que se atiende con antibióticos. “De lo que hablo es de antibióticos intravenosos durante al menos dos semanas, seguidos de tres a seis meses de antibióticos orales”, detalló Petras.
Los pacientes se tratan primero por vía intravenosa con Meropenem (Merrem) y ceftazidima (Fortaz). Luego se les administra amoxicilina en pastillas.
Los síntomas dependen del lugar en el que se haya infectado la persona, pero pueden incluir:
- Fiebre
- Dolor o hinchazón
- Úlceras
- Tos
- Dolor en el pecho
- Dificultad para respirar
- Pérdida de peso
- Dolor muscular o articular
- Desorientación
- Dolor de cabeza
- Convulsiones
Los síntomas evolucionan hasta convertirse en neumonía, abscesos e infecciones sanguíneas.